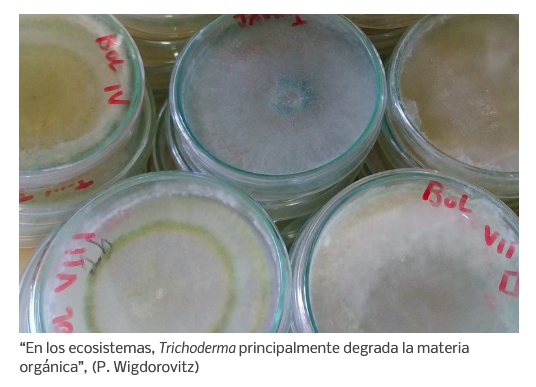
Captura de Pantalla 2023 07 06 a las 14.20.27
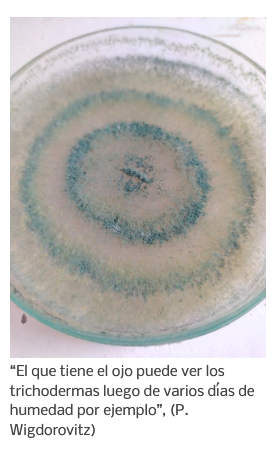
Captura de Pantalla 2023 07 06 a las 14.20.55

Hongos para mejorar rindes en cultivos intensivos y extensivos
Publicado el: 07 Julio 2023
Autor: SLT
Con cepas nativas del género fúngico Trichoderma, investigadores de la FAUBA lograron aumentar el peso de plantines de lechuga y el rendimiento del trigo.
Generaron bioproductos que podrían contribuir a reducir el uso de agroquímicos.
(SLT-FAUBA) Los hongos se encuentran en todos lados. En nuestra piel, en ríos, en platos gourmet y hasta en series de televisión. En el agro, existen algunos que perjudican a los cultivos, pero por suerte hay otros que los favorecen. Investigadores de la Facultad de Agronomía de la UBA (FAUBA) aislaron cepas nativas del género de hongos Trichoderma para mejorar la sanidad y el rinde de cultivos intensivos y extensivos. Ya lograron incrementar un 40% el peso de plantines de lechuga y un 20% el rendimiento del trigo. Dentro de esta línea de trabajo se elaboran productos biológicos que podrían ayudar a disminuir el uso de productos de síntesis química en el sector.
“Trichoderma es un género de hongos que se encuentra en los suelos de todo el planeta. Si bien en muchos países se lo estudia hace tiempo por sus efectos benéficos para los cultivos, en la Argentina, su investigación es más reciente. El grupo de trabajo que integro recolecta y aisla cepas nativas de Trichoderma en suelos de zonas hortícolas del Área Metropolitana de Buenos Aires con la idea de estudiar cómo afectan el crecimiento de diversos cultivos”, explicó Patricio Wigdorovitz, docente de Fitopatología en la FAUBA.
“Trabajamos con lechuga en la localidad de La Plata y con trigo en la zona pampeana. Los elegimos como ejemplos típicos de cultivos intensivos y extensivos. Probamos casi 30 cepas de Trichoderma y encontramos que varias de ellas generaban efectos positivos. Una aumentó casi 40% el peso de plantines de lechuga, y otra incrementó cerca del 20% el rendimiento del trigo”, resaltó.

Patricio agregó que los efectos positivos de estos microorganismos se explican de diferentes maneras. “Por un lado, fomentan la producción de biomasa de algunas plantas, ya que generan compuestos similares a las hormonas vegetales que promueven el crecimiento. Por otro lado, en base a su gran capacidad de colonizar los suelos evitan que proliferen otros hongos que dañan a los cultivos”, afirmó a partir de sus estudios de doctorado que lleva a cabo en la Escuela para Graduados ‘Alberto Soriano’ (FAUBA).
Más Trichoderma, menos agroquímicos
http://sobrelatierra.agro.uba.ar/wp-content/uploads/2023/06/Trichoderma-en-Placa-de-Petri-225x300.jpg 225w" alt="“El que tiene el ojo puede ver los trichodermas luego de varios días de humedad por ejemplo”, (P. Wigdorovitz)" width="256" height="341" class="wp-image-16288" style="margin: 0px; padding: 0px; border: 0px; font: inherit; vertical-align: bottom; max-width: 100%; height: auto;" title="“El que tiene el ojo puede ver los trichodermas luego de varios días de humedad por ejemplo”, (P. Wigdorovitz)" />
“El que tiene el ojo puede ver los trichodermas luego de varios días de humedad por ejemplo”, (P. Wigdorovitz)
En este contexto, Wigdorovitz destacó que desarrollar un producto biológico basado en Trichoderma podría ayudar a aquellos productores que buscan usar menos agroquímicos en sus campos. “Hay muchos productores que quieren cambiar sus sistemas hacia otros más orgánicos, más agroecológicos, y muchas veces se encuentran con limitaciones. Mediante Trichoderma podemos favorecer esa transición”.
Además, añadió que los hongos en cuestión soportan aplicaciones de fungicidas en dosis relativamente bajas. “Esto posibilita usarlo en producciones del tipo convencional, sobre todo en sistemas intensivos hortícolas”.
Productos biológicos para el futuro
Wigdorovitz contó que en el suelo se pueden encontrar muchas cepas de Trichoderma, pero que no todas funcionan de la misma manera. “Depende de las cepas, de los aislados y de las especies con las que se relacionan, y por eso hay que realizar varios ensayos”.
Junto con Eduardo Wright, el director de su doctorado, Patricio y otros compañeros de la FAUBA crearon, con el apoyo de IncUBAgro —una iniciativa de la FAUBA que promueve los emprendimientos innovadores vinculados al agro—, la empresa Airu, que investiga y elabora insumos biológicos para la producción agropecuaria. Trabajan con Trichoderma y con otros hongos, llamados entomopatógenos, que controlan insectos plaga.
Para cerrar, Patricio reflexionó: “Muchos productores tuvieron experiencias negativas con productos biológicos porque hay mucho mercado negro. En ocasiones, hicimos pruebas con insumos que supuestamente tenían Trichoderma, y no lo encontramos. En nuestra interacción con productores, también luchamos contra ese fantasma, pero en general nos reciben de buena forma”.
Fuente: Sobre la Tierra